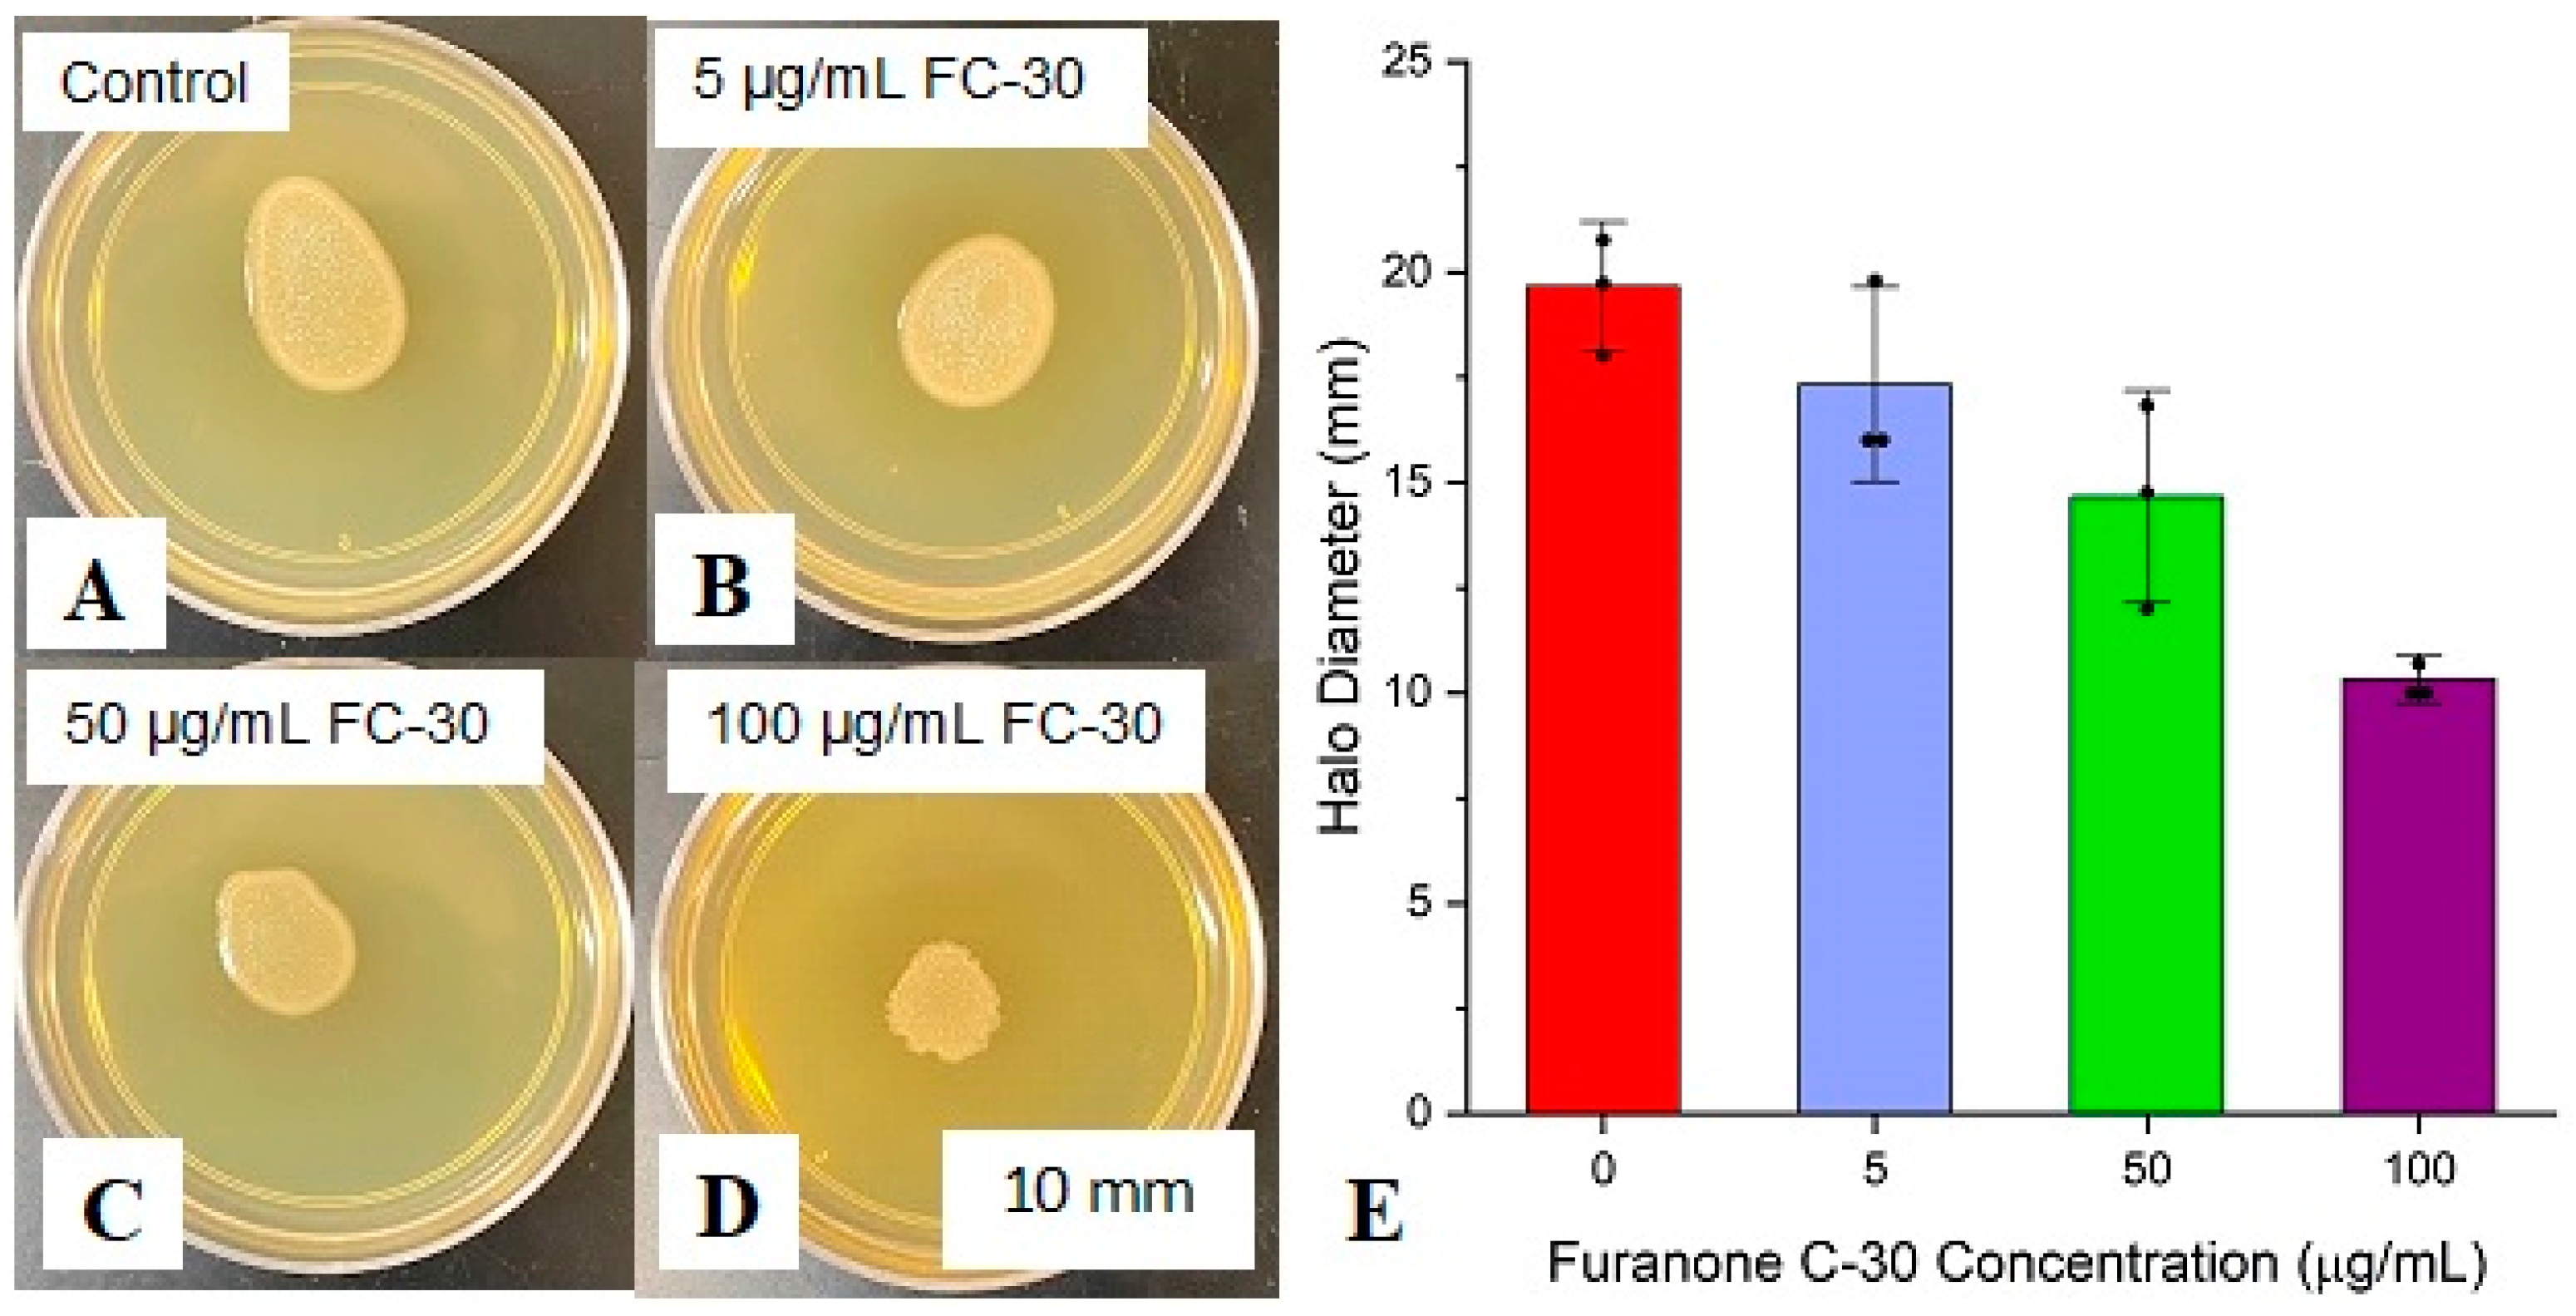
Coatings 14 00070 g002

Quorum Quenching Nanofibers for Anti-Biofouling Applications
Abstract
1. Introduction
2. Experiment
2.1. Materials
2.2. Bacterial Culture
2.3. Anti-Quorum-Sensing Activity
2.4. Electrospinning Parameters
2.5. Fiber Stability in Aqueous Environments
2.6. Biofouling Simulation and Bench-Scale Testing
2.7. Scanning Electron Microscopy
2.8. Confocal Microscopy
3. Results and Discussions
3.1. Antibacterial Action of Furanone C-30 and Curcumin
3.2. Controlled Release Mechanism
3.3. Anti-QS Performance of Electrospun Surface
3.4. Nanofiltration Application of the Furanone C-30-Functionalized Membranes
4. Conclusions
Author Contributions
Funding
Institutional Review Board Statement
Informed Consent Statement
Data Availability Statement
Acknowledgments
Conflicts of Interest
References
- Vertes, A.; Hitchins, V.; Phillips, K.S. Analytical challenges of microbial biofilms on medical devices. Anal. Chem. 2012, 84, 3858–3866. [Google Scholar] [CrossRef] [PubMed]
- Qiu, H.; Feng, K.; Gapeeva, A.; Meurisch, K.; Kaps, S.; Li, X.; Yu, L.; Mishra, Y.K.; Adelung, R.; Baum, M. Functional polymer materials for modern marine biofouling control. Prog. Polym. Sci. 2022, 127, 101516. [Google Scholar] [CrossRef]
- Amin, N.A.A.M.; Mokhter, M.A.; Salamun, N.; Mohamad, M.F.; bin Mahmood, W.M.A.W. Anti-fouling electrospun organic and inorganic nanofiber membranes for wastewater treatment. South Afr. J. Chem. Eng. 2023, 44, 302–317. [Google Scholar] [CrossRef]
- Silva, E.; Ferreira, O.; Ramalho, P.; Azevedo, N.; Bayón, R.; Igartua, A.; Bordado, J.; Calhorda, M. Ecofriendly non-biocide-release coatings for marine biofouling prevention. Sci. Total Environ. 2019, 650, 2499–2511. [Google Scholar] [CrossRef]
- Jones, I.A.; Joshi, L.T. Biocide use in the antimicrobial era: A review. Molecules 2021, 26, 2276. [Google Scholar] [CrossRef] [PubMed]
- Shineh, G.; Mobaraki, M.; Perves Bappy, M.J.; Mills, D.K. Biofilm Formation, and Related Impacts on Healthcare, Food Processing and Packaging, Industrial Manufacturing, Marine Industries, and Sanitation—A Review. Appl. Microbiol. 2023, 3, 629–665. [Google Scholar] [CrossRef]
- Schultz, M.P.; Bendick, J.A.; Holm, E.R.; Hertel, W.M. Economic impact of biofouling on a naval surface ship. Biofoulinsg 2011, 27, 87–98. [Google Scholar] [CrossRef]
- Lewis, J.A. Non-silicone biocide-free antifouling solutions. In Advances in Marine Antifouling Coatings and Technologies; Elsevier: Amsterdam, The Netherlands, 2009; pp. 709–724. [Google Scholar] [CrossRef]
- Taiswa, A.; Andriolo, J.M.; Katie Hailer, M.; Skinner, J.L. Electrospun controlled release anti-quorum sensing filter for biofouling prevention in MCE membranes. Sep. Purif. Technol. 2024, 332, 125874. [Google Scholar] [CrossRef]
- Nwuzor, I.C.; Idumah, C.I.; Nwanonenyi, S.C.; Ezeani, O.E. Emerging trends in self-polishing anti-fouling coatings for marine environment. Saf. Extrem. Environ. 2021, 3, 9–25. [Google Scholar] [CrossRef]
- Amara, I.; Miled, W.; Ben Slama, R.; Ladhari, N. Antifouling processes and toxicity effects of antifouling paints on marine environment. A review. Environ. Toxicol. Pharmacol. 2018, 57, 115–130. [Google Scholar] [CrossRef]
- Taiswa, A.; Andriolo, J.M.; Zodrow, K.R.; Skinner, J.L. Polydopamine-copper spacers improve longevity and prevent biofouling in reverse osmosis. Water Supply 2022, 22, 7782–7793. [Google Scholar] [CrossRef]
- Viju, N.; Anitha, A.; Vini, S.S.; Shankar, C.V.; Satheesh, S.; Punitha, S. Antibiofilm activities of extracellular polymeric substances produced by bacterial symbionts of seaweeds. Indian J. Geo-Mar. Sci. 2014, 43, 2136–2146. [Google Scholar]
- Achinas, S.; Charalampogiannis, N.; Euverink, G.J.W. A Brief Recap of Microbial Adhesion and Biofilms. Appl. Sci. 2019, 9, 2801. [Google Scholar] [CrossRef]
- Ashfaq, M.Y.; Al-Ghouti, M.A.; Zouari, N. Investigating the effect of polymer-modified graphene oxide coating on RO membrane fouling. J. Water Process. Eng. 2022, 49, 103164. [Google Scholar] [CrossRef]
- Chen, H.; Xu, C.; Zhao, F.; Geng, C.; Liu, Y.; Zhang, J.; Kang, Q.; Li, Z. Designing the anti-biofouling surface of an ultrafiltration membrane with a novel zwitterionic poly(aryl ether oxadiazole) containing benzimidazole. Appl. Surf. Sci. 2023, 609, 155447. [Google Scholar] [CrossRef]
- Zhang, N.; Cheng, K.; Zhang, J.; Li, N.; Yang, X.; Wang, Z. A dual-biomimetic strategy to construct zwitterionic anti-fouling membrane with superior emulsion separation performance. J. Memb. Sci. 2022, 660, 120829. [Google Scholar] [CrossRef]
- Jeong, S.; Kim, H.-W. In situ real-time monitoring technologies for fouling detection in membrane processes. In Current Developments in Biotechnology and Bioengineering; Elsevier: Amsterdam, The Netherlands, 2023; pp. 43–64. [Google Scholar] [CrossRef]
- Kim, D.Y.; Kim, M.; Jeon, S.; Lee, J.; Park, H.; Park, Y.-I.; Park, S.-J.; Lee, J.-H. In situ modification of ultrafiltration membranes with eco-friendly pyrogallol/taurine to enhance antifouling performance. J. Memb. Sci. 2023, 688, 122114. [Google Scholar] [CrossRef]
- Feng, Y.; Liang, J.; Liu, X.; Gao, K.; Zhang, Y.; Li, A.; Chen, C.; Hou, L.-A.; Yang, Y. Graphene oxide/methyl anthranilate modified anti-biofouling membrane possesses dual functions of anti-adhesion and quorum quenching. J. Memb. Sci. 2023, 668, 121265. [Google Scholar] [CrossRef]
- Wang, R.; An, Z.; Fan, L.; Zhou, Y.; Su, X.; Zhu, J.; Zhang, Q.; Chen, C.; Lin, H.; Sun, F. Effect of quorum quenching on biofouling control and microbial community in membrane bioreactors by Brucella sp. ZJ1. J. Environ. Manag. 2023, 339, 117961. [Google Scholar] [CrossRef]
- Zhang, X.; Ma, B.; Zhang, N.; Zhang, H.; Ma, Y.; Song, Y.; Zhang, H. Regulating performance of CANON process via adding external quorum sensing signal molecules in membrane bioreactor. Bioresour. Technol. 2023, 369, 128465. [Google Scholar] [CrossRef]
- González, J.E.; Keshavan, N.D. Messing with Bacterial Quorum Sensing. Microbiol. Mol. Biol. Rev. 2006, 70, 859–875. [Google Scholar] [CrossRef] [PubMed]
- Miller, M.B.; Bassler, B.L. Quorum Sensing in Bacteria. Annu. Rev. Microbiol. 2001, 55, 165–199. [Google Scholar] [CrossRef] [PubMed]
- Andriolo, J.M.; Sutton, N.J.; Murphy, J.P.; Huston, L.G.; Kooistra-Manning, E.A.; West, R.F.; Pedulla, M.L.; Hailer, M.K.; Skinner, J.L. Electrospun Fibers for Controlled Release of Nanoparticle-Assisted Phage Therapy Treatment of Topical Wounds. MRS Adv. 2018, 3, 3019–3025. [Google Scholar] [CrossRef]
- Proctor, C.R.; Taggart, M.G.; O’Hagan, B.M.; McCarron, P.A.; McCarthy, R.R.; Ternan, N.G. Furanone loaded aerogels are effective antibiofilm therapeutics in a model of chronic Pseudomonas aeruginosa wound infection. Biofilm 2023, 5, 100128. [Google Scholar] [CrossRef]
- Wei, J.; Zhang, X.; Zhang, Z.; Ding, X.; Li, Y.; Zhang, Y.; Jiang, X.; Zhang, H.; Lai, H.; Shi, J. Switch-on mode of bioenergetic channels regulated by curcumin-loaded 3D composite scaffold to steer bone regeneration. Chem. Eng. J. 2023, 452, 139165. [Google Scholar] [CrossRef]

Disclaimer/Publisher’s Note: The statements, opinions and data contained in all publications are solely those of the individual author(s) and contributor(s) and not of MDPI and/or the editor(s). MDPI and/or the editor(s) disclaim responsibility for any injury to people or property resulting from any ideas, methods, instructions or products referred to in the content. |
© 2024 by the authors. Licensee MDPI, Basel, Switzerland. This article is an open access article distributed under the terms and conditions of the Creative Commons Attribution (CC BY) license (https://creativecommons.org/licenses/by/4.0/).
Share and Cite
Taiswa, A.; Andriolo, J.M.; Hailer, M.K.; Skinner, J.L. Quorum Quenching Nanofibers for Anti-Biofouling Applications. Coatings 2024, 14, 70. https://doi.org/10.3390/coatings14010070
Taiswa A, Andriolo JM, Hailer MK, Skinner JL. Quorum Quenching Nanofibers for Anti-Biofouling Applications. Coatings. 2024; 14(1):70. https://doi.org/10.3390/coatings14010070
Chicago/Turabian StyleTaiswa, Amos, Jessica M. Andriolo, M. Katie Hailer, and Jack L. Skinner. 2024. "Quorum Quenching Nanofibers for Anti-Biofouling Applications" Coatings 14, no. 1: 70. https://doi.org/10.3390/coatings14010070
APA StyleTaiswa, A., Andriolo, J. M., Hailer, M. K., & Skinner, J. L. (2024). Quorum Quenching Nanofibers for Anti-Biofouling Applications. Coatings, 14(1), 70. https://doi.org/10.3390/coatings14010070

